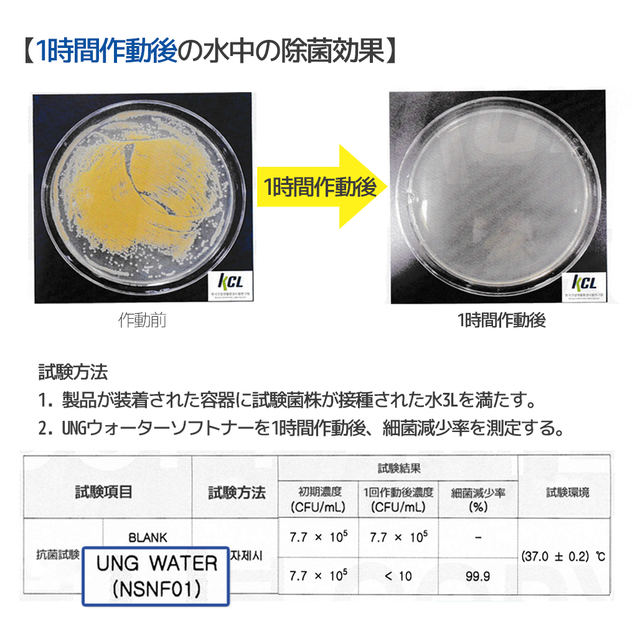
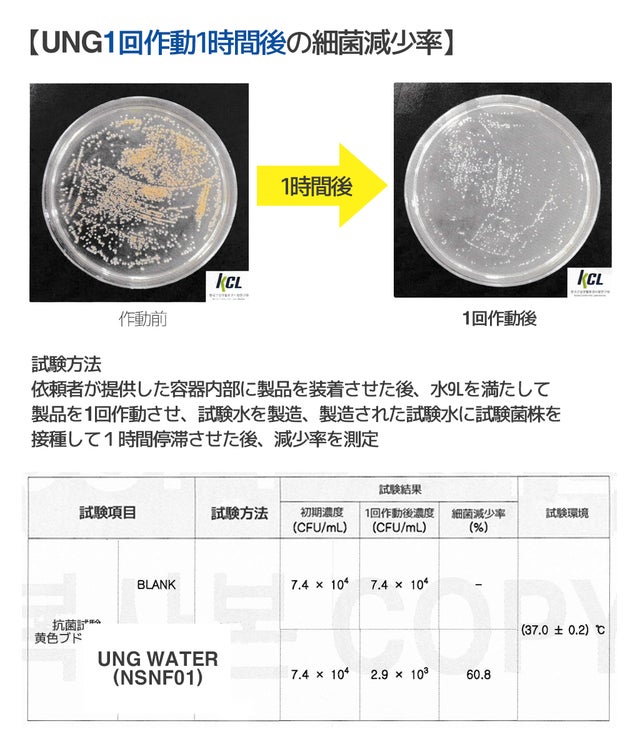
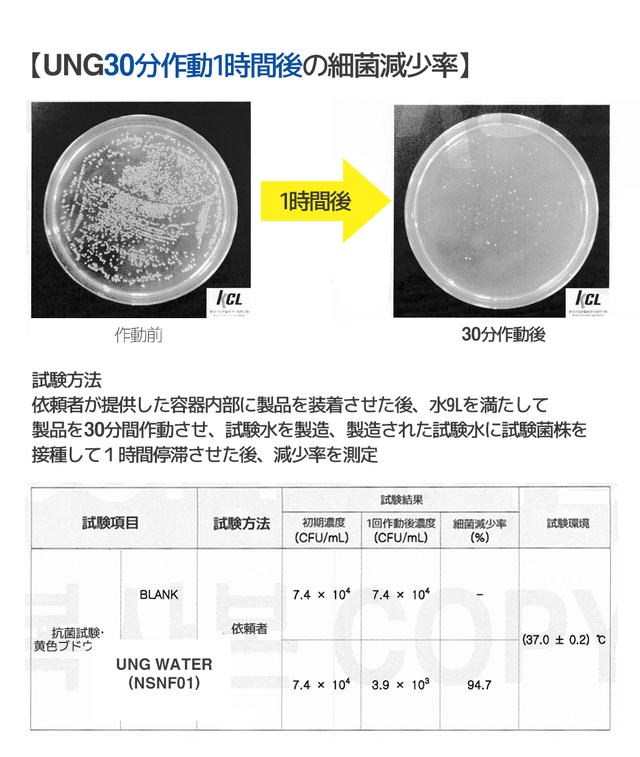

プロジェクト実行者
ストーリー
- NOフィルター・NO充電・半永久的に使用可能軟水器
- 無機質分子の安定化による洗浄力UP、頭の角質をスッキリ洗浄!
- 静電系技術で水を除菌、シャワーホースの腐食を防止・除去!




UNGウォーターソフトナーは、自家発電ターボで電力の必要がなく使用可能な家庭用ミニ軟水器です。

①UNGウォーターソフトナーの内蔵されたターボ発電機により、高い静電場の電位が水に供給されて細菌を除菌します。
②弱体化された水の分子の水素結合は、水の表面張力を落として水の洗浄力を向上させます。
③洗浄力を落とすカルシウム·マグネシウムなどイオンを活性化し、コロイド分子の形にし、水を軟水化させボディシャンプーやシャンプーなどの洗浄力を向上させます。


UNGウォーターソフトナー4つの特徴


韓国衣類試験研究院が行った水道水による硬度検査によりますとUNGウォーターソフトナーの使用後は硬度が約15%下がり、ソフトで洗浄力の高い水に軟水化されたことが分かりました。

UNGウォーターソフトナーを取り付けるだけで、やわらかくなった水の流れを感じることができます。
【純粋な水を生産】

静電系技術によって水の分子が活性化され、純粋できれいな水を生産します。



シャワーのホースやシャワー本体の腐食が始まると、シャワーホース内部のサビ、石灰、銅などの肌に良くない有害成分が水と一緒に流れ体に良くない影響を与えることがあります。
UNGウォーターソフトナーは水アカ等を除去し、サビや水のヌメリを発生させないように防止する役割を果たします。
※本製品はフィルターなしで静電系を利用してサビや水垢を除去又は防止しますのでフィルターの軟水器を使用した時のように濾した後のサビが内部に残っていません。


静電系技術を利用
内蔵されたターボ発電機と制御器による静電場の転位を利用し、除菌処理をしてイオンを活性化させます。そして、コロイドを安定的に分散させ水を浄化させます。

試験方法
1.製品が装着された容器に試験菌株が接種された水3Lを入れました。
2.UNGウォーターソフトナーを1回通過した後、細菌減少率を測定する。
結果、細菌が減少する効果!


UNGウォーターソフトナーは洗浄力を強化します。
洗浄力を低下させる無機質分子を安定させ、石鹸やシャンプー、ボディソープなどの洗浄力を強化します。

石鹸やシャンプー、ボディソープの洗浄力向上
肌表面の油や角質などを吸着させ、肌から分離させて肌をきれいにします。

洗浄力試験によると、UNGウォーターソフトナーを使用する前と使用後の洗浄力が17%も改善されたことが確認できます。

ボディシャンプーなどに弱い敏感肌の方のクレンジングもしっかりサポートしてくれます。


①優れた洗浄力で頭皮の角質を綺麗に

②ダメージヘアのキューティクルケア


③フィルターなしで除菌効果

1回の作動でも細菌の過半数以上が減少することが確認できます。
1時間作動後には細菌がほとんど残っていないことが確認できます。
④ UNG軟水器を通過した水の除菌効果

UNGウォーターソフトナーを1回作動1時間後の細菌の減少率を示しています。
30分間作動、1時間後には細菌がほとんど残っていないことが分かりました。
UNGウォーターソフトナーから出た水は抗菌効果があり、トイレの壁や床など表面にいる細菌を減少させる効果があります。
UNGウォーターソフトナーのきれいなお水

⑤自家発電のため、充電する必要がなく半永久的に使用可能

UNGウォーターソフトナーは、バッテリーとフィルターの交換が不要な軟水装置です。
静電系を利用して洗浄力を高め、水中の除菌はもちろん!サビ水のヌメリを除去·防止します。
取り付け方法も簡単で、製品を受け取っていただいてセルフで十分設置可能です。
半永久的に使用でき、追加で消耗品が入らないというメリットがあります。
⑥どこにでも合う洗練されたデザイン

本体の重量350gの軽さとコンパクトなサイズでご希望の場所に取付可能です。



お風呂やユニットバスまで、どこにでも合う洗練されたデザイン


【アダプターなしで対応可能なメーカー】
INAX(バランス窯・スイッチシャワー以外)SAN-EI/KAKUDAI/MYM/YuKo(2001年以降製造品)
【別途アダプターの購入が必要なメーカー】
TOTO/KVK/東京ガス/大阪ガス/ミズタニ/INAX(バランス窯・スイッチシャワー)/リンナイ/YUKO(2001年以前製造品)
※ご使用の前に設置予定の水道の水栓のタイプをご確認の上、対応していない水栓タイプの場合はホームセンターなどで互換アダプターを別途お求めください。
また上記記載のアダプターが合わない場合は、カスタマーセンター( ungtechno@gmail.com)へお問い合わせ下さい。

UNGウォーターソフトナーは静電系を利用した家庭用水質改善製品で、シンガポールなどの国内外事業場に使用されました。
※こちらは自社で行いましたテストの結果です。
※実際の使用環境での同じ効果を保証するものではありません。

UNGウォーターソフトナーの国内外特許及び認証事項
誰でも出来る簡単取り付け方法



製品詳細

メーカーご紹介

こんにちは。UNG Technology です。
2008年に設立されたUNGテクノロジーは、きれいで安全な世界で健康な生活を送り、より良い環境を作るためのエコ環境企業へと成長しました。
人類文明を明らかにした電気エネルギー源を作るのに必要な核心部品であるモーター、電力変換装置の設計分野において世界的なレベルの源泉技術を保有する企業として、日本、中国、シンガポール、アセアン、EUなどに韓国製品を輸出しています。
産業が高度化されるほど私たちの環境は病んでいきます。
特に水質汚染は人類生態系の持続可能性を脅かしていると考え、10年前から水質に関する研究を長年行ってきた結果、水質を画期的に改善できる静電系方式の水質改善装備を開発しました。
FAQ
Q.製品の設置方向はありますか?
A.作動が確認できるようLEDランプが正面に見えるように設置してください。
Q.同梱スパナの前後サイズが異なる理由は何ですか?
A.ウォーターソフトナー上部を混合栓に固定する場合は、小さいサイズのスパナを使用し、シャワーホースにつなぐ場合は大きいサイズのスパナを使用して固定してください。
Q.使用説明書に同封のゴムリングはどこに使用しますか?
A.本体の入口と出口部分に、水漏れを防止するためにゴムリングを挿入して使用してください。 同梱のゴムリングは本体上部に取り付けて、本体下部のゴムリングは従来のシャワー機に取り付けてあるものをそのままお使いください。
※同梱のゴムリングは、本体の上部にのみ使用してください。
Q.シャワーとの接続はどうしますか?
A.本体の水気を取った後、手で滑らないようにしっかりとつかんだ後、同封のスパナで回して締めます。 この時、強く締めすぎると本体とシャワーの継ぎ目部分が歪んだり破損したりして、水漏れを起こす恐れがありますのでご注意ください。
Q.本体に水気があったり、内部から水が出ていますが、製品の不良ではありませんか?
A. 生産された製品の最終品質検査過程である"漏水テスト"により水気があったり、水が残っている場合があります。不良品ではありません。
Q:本体は分解できますか?
A. 本製品は、絶縁を確実にするため本体の内部に絶縁材で充電されており分解が不可能な構造です。
したがって、分解による破損及び故障は無償保証期間であっても、補償規定に基づき有償修理されます。
Q.上水道以外の水に使用してもよいですか?
A.家庭内の標準上水道を原水で使用してください。 お湯は摂氏70度以下で使用することをお勧めします。
Q:製品管理の方法はありますか?
A.特に管理する必要はありません。 しかし長期間使用する事により外部に水アカにより光沢が落ちる場合がございます。 その時シンナーやベンゼンなどの薬品を使ったり、金属たわしなどを使用するとメッキが剥がれることがありますので、水気を取ってから柔らかい布やタオルで拭いてください。
Q.LEDセンサーが点滅する理由はありますか?
A. 本製品はシャワーの水圧に応じてLEDセンサーが作動します。 最初のLEDライトの点滅は動作開始をお知らせし、水圧が弱いとLEDが弱く点滅したり点灯しない場合がありますが、これは正常に動作しておりますので安心してお使いください。
Q:幼虫や石灰は除去されますか?
A. 本製品はフィルターや薬品を使用していないため、幼虫や石灰が除去される方式ではなく静電系効果で死滅したり、イオンが活性化したりします。 このような不純物はシャワーを通して排出され、ソフトナー水と反応した石鹸水で体からきれいに洗い流されます。
Q:音が出ますが、故障ではありませんか?
A:本製品には、自家ターボ発電機が内蔵されており、発電機が動く音が聞こえることがあります。 水の水圧によって発電機が動きますので、音が多少大きく聞こえる場合がありますが、正常に作動しているのでどうぞご安心して使用してください。
リスク&チャレンジ
※製品は既に完成していますが、生産状況・天候・配送問題などで、輸送が遅延する可能性がございますので、ご留意ください。 ※ご支援の数が想定を上回った場合、製造工程上の都合等により出荷時期が遅れる場合がございます。 ※並⾏輸⼊品が発⽣する可能性があります。個⼈輸⼊及び販路によっては防ぐことができない可能性がありますのでご了解ください。 ※使用感等に関する返品・返金はお受けいたしかねます。 ※お客様の都合によるキャンセルや返金は受付致しませんので、ご了承ください。
サポーターからの応援コメント
文章のトップに戻る
応援購入する
このプロジェクトはAll in型です。目標金額の達成に関わらず、プロジェクト終了日の2021年08月30日までに支払いを完了した時点で購入が成立します。
【超早割】NO充電・NOフィルターUNGウォーターソフトナーX 1

14,000円(税込)
【超早割】NO充電・NOフィルターUNGウォーターソフトナー
【一般販売予定価格20,000円の30%OFF】
【セット内容】
・UNGウォーター ソフトナー本体1個
・ゴムリング1個
・スパム1個
※ご注文状況、使用部材の供給状況、製造工程上の都合等により出荷時期が遅れる場合があります。
※皆様のご支援により量産効率が向上した場合、正規販売価格が販売予定価格より下がる可能性もございます。
【早割】NO充電・NOフィルターUNGウォーターソフトナー X 1

16,000円(税込)
【超早割】NO充電・NOフィルターUNGウォーターソフトナー
【一般販売予定価格20,000円の20%OFF】
【セット内容】
・UNGウォーター ソフトナー本体1個
・ゴムリング1個
・スパム1個
※ご注文状況、使用部材の供給状況、製造工程上の都合等により出荷時期が遅れる場合があります。
※皆様のご支援により量産効率が向上した場合、正規販売価格が販売予定価格より下がる可能性もございます。
「Makuake(マクアケ)」は、実行者の想いを応援購入によって実現するアタラシイものやサービスのプラットフォームです。このページは、 プロダクトカテゴリの 「自家静電系技術を利用して頭皮角質をしっかり洗浄!UNGウォーターソフトナー軟水器」プロジェクト詳細ページです。








